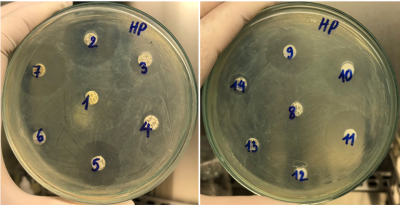
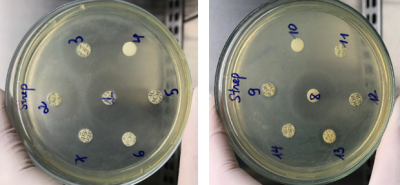
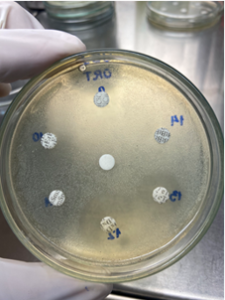

THƯ VIỆN ẢNH
1. Hình ảnh kháng sinh đồ vi khuẩn Haemophilus parasuis

2. Hình ảnh kháng sinh đồ Streptococcus suis

3. Hình ảnh kháng sinh đồ vi khuẩn ORT

1. Hình ảnh kháng sinh đồ vi khuẩn Haemophilus parasuis
2. Hình ảnh kháng sinh đồ Streptococcus suis
3. Hình ảnh kháng sinh đồ vi khuẩn ORT